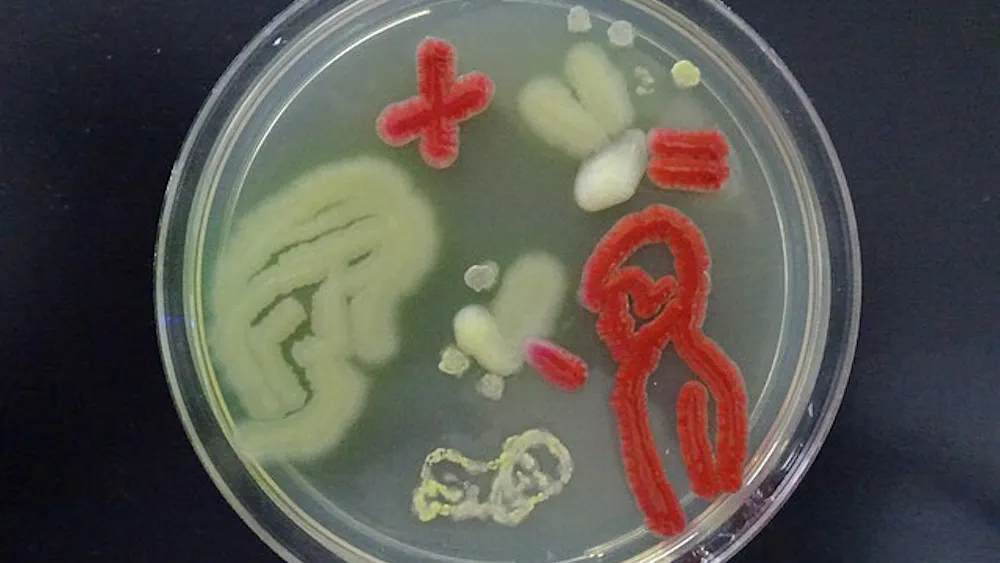
COURTESY OF AJAY KUMAR CHAURASIYA / CREATIVE COMMONS
A PhD student William Brakewood is undertaking a new venture: the creation of the start-up Microbiome Foundries.

Can Physics Stop Climate Change? A Seminar by Brad Marston
By AMELIA JOSEPH | May 2, 2026Brad Marston, a Physics professor at Brown University, gave a seminar on Thursday, April 23rd, 2026 titled, ‘Can Physics Stop Climate Change?’, organized by the Department of Physics and Astronomy.